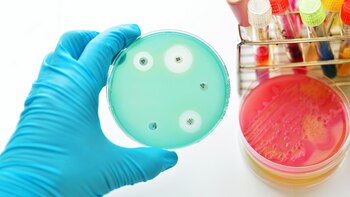
Uno de los desafíos de

Científicos descubrieron en una prueba de tierra extraída en Italia un nuevo antibiótico que es eficiente contra las bacterias resistentes.
Este nuevo antibiótico, producido por un microbio, que fue bautizado como "pseudouridimycine" (PUM), logró destruir una amplia gama de bacterias, muchas de las cuales resistentes, durante las pruebas de laboratorio. También fue capaz de curar la escarlata en ratones.
El descubrimiento fue publicado el jueves en un artículo de la revista científica estadounidense Cell.
El pseudouridimycine neutraliza la polimerasa, una encima esencial para todas las funciones de cada organismo.
Sin embargo, su mecanismo es diferente al de la rifampicina, una clase de antibiótico que también esta dirigido a la misma enzima. También es diez veces menos de susceptible de desencadenar resistencia como los antibióticos que hay en el mercado.
PUM mató a veinte especies de bacterias de laboratorio y fue particularmente eficaz contra los estreptococos y estafilococos, que son muchas veces resistentes a múltiples antibióticos.
Los ensayos clínicos con este nuevo antibiótico podrían comenzar en tres años y llegar al mercado dentro de 10 años, indicaron los investigadores de la universidad Rutgers-New Brunswick y la firma italiana de biotecnologías Naicons.
Este descubrimiento demuestra una vez más que las bacterias que se encuentran en el suelo son la mejor fuente de nuevos antibióticos, subrayó el científico.
(Con información de AFP)
LEA MÁS:
Antibióticos en alimentos: riesgos y alternativas de una práctica polémica
Un antibiótico "superpoderoso", ¿la solución frente a las resistencias bacterianas?
Cuáles son las nuevas categorías de antibióticos creadas por la OMS
Últimas Noticias
Venezuela anunció dos nuevos cambios en el mando militar
Se trata de los comandantes de las Zonas de Defensa Integral en los estados Trujillo y Nueva Esparta

Manifestaciones, accidentes y bloqueos en CDMX y Edomex hoy 23 de enero: tránsito lento en Av. 608 rumbo avenida Oceanía
Mantente informado en tiempo real sobre el acontecer del Valle de México

La reflexión de Julio Rodríguez, el adolescente de 16 años que participó junto a su amigo en las labores de rescate de Adamuz: “La vida puede cambiar en cuestión de segundos”
El joven fue de los primeros en llegar al lugar, siguiendo a los servicios de emergencia y guiado por los reclamos de auxilio: “Había mucha gente que salvar”

Sigue la suba de tasas de plazos fijos: cuánto hay que depositar para ganar $100 mil de intereses
El aumento de las tasas bancarias redefine el escenario para quienes buscan proteger el valor de sus ahorros en un contexto de inflación persistente


